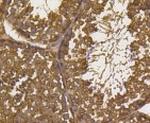
UBB Antibody in Immunohistochemistry (Paraffin) (IHC (P))

Search
Abnova
UBB Recombinant Rabbit Monoclonal Antibody
{{$productOrderCtrl.translations['antibody.pdp.commerceCard.promotion.promotions']}}
{{$productOrderCtrl.translations['antibody.pdp.commerceCard.promotion.viewpromo']}}
{{$productOrderCtrl.translations['antibody.pdp.commerceCard.promotion.promocode']}}: {{promo.promoCode}} {{promo.promoTitle}} {{promo.promoDescription}}. {{$productOrderCtrl.translations['antibody.pdp.commerceCard.promotion.learnmore']}}

Please note: We are reviewing Western blot images included in the antibody testing data in our catalog, including those provided by third parties. Unless expressly labeled or annotated as “raw-unedited”, Western blot images included in the antibody testing data in our catalog may have been edited, optimized or otherwise adjusted for presentation.
产品信息
RAB02749
种属反应
宿主/亚型
Expression System
分类
类型
偶联物
形式
纯化类型
保存液
内含物
保存条件
运输条件
靶标信息
Ubiquitin is a highly conserved protein of about 8.5 kDa molecular weight, which has an ATP dependent role in the targeting of proteins for proteolytic degradation. To perform this function, the protein to be degraded is first covalently attached to the C terminus of ubiquitin, and the ubiquitinated complex is then recognized by a complex of degradative enzymes. Interestingly, ubiquitin also becomes covalently bonded to many types of pathological inclusions, which appear to be resistant to normal degradation. Therefore, ubiquitin antibodies are very useful for studies of these inclusions. For example, the neurofibrillary tangles and paired helical filaments diagnostic of Alzheimer's disease, Lewy bodies seen in Parkinson's disease, and Pick bodies found in Pick's disease are all heavily ubiquitinated and can be readily visualized with ubiquitin antibodies.
仅用于科研。不用于诊断过程。未经明确授权不得转售。
篇参考文献 (0)
生物信息学
蛋白别名: HUBCEP52; MGC127041; Polyubiquitin-B; RPL40; ubiquitin C
基因别名: AL033289; Rps27a; Uba52; UBB; Ubb2; UBC
UniProt ID: (Mouse) P0CG49, (Rat) P0CG51
Entrez Gene ID: (Mouse) 22187, (Rat) 192255



